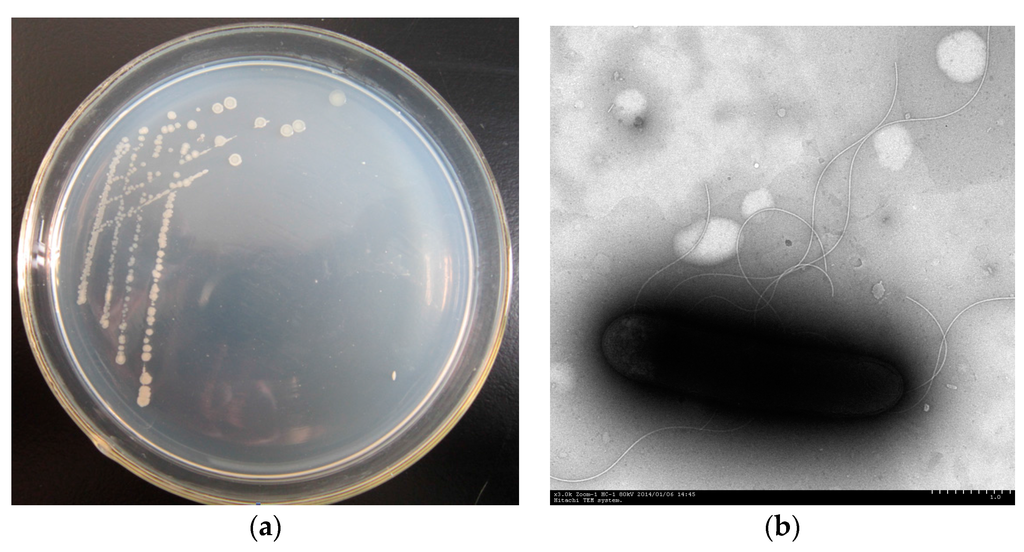

Abstract
Endophytes are ubiquitous in plants, and they may have a natural capacity to biodegrade polycyclic aromatic hydrocarbons (PAHs). In our study, a phenanthrene-degrading endophytic Paenibacillus sp. PHE-3 was isolated from P. asiatica L. grown in a PAH-contaminated site. The effects of environmental variables on phenanthrene biodegradation by strain PHE-3 were studied, and the ability of strain PHE-3 to use high molecular weight PAH (HMW-PAH) as a sole carbon source was also evaluated. Our results indicated that pH value of 4.0–8.0, temperature of 30 °C–42 °C, initial phenanthrene concentration less than 100 mg·L−1, and some additional nutrients are favorable for the biodegradation of phenanthrene by strain PHE-3. The maximum biodegradation efficiency of phenanthrene was achieved at 99.9% after 84 h cultivation with additional glutamate. Moreover, the phenanthrene biodegradation by strain PHE-3 was positively correlated with the catechol 2,3-dioxygenase activity (ρ = 0.981, p < 0.05), suggesting that strain PHE-3 had the capability of degrading HMW-PAHs. In the presence of other 2-, 3-ringed PAHs, strain PHE-3 effectively degraded HMW-PAHs through co-metabolism. The results of this study are beneficial in that the re-colonization potential and PAH degradation performance of endophytic Paenibacillus sp. PHE-3 may be applied towards reducing PAH contamination in plants.
1. Introduction
With increasing anthropogenic activities, polycyclic aromatic hydrocarbons (PAHs) pose substantial concerns owing to their widely known potential toxicity. PAHs containing more than three aromatic rings have been referred to as high molecular weight (HMW) PAHs in the environmental microbiology literature. PAHs containing four fused benzene rings are classed as recalcitrant, and not easily being degraded. Due to their elevated octanol-water partition coefficients (Kow), HMW-PAHs may separate into organic phases, soil and sediment organic matter, and membranes of living organisms [1]. An abundance of HMW-PAHs was found in vegetables from contamination sites [2]. Biomagnifications of HMW-PAHs through trophic transfer to food webs pose potential risks to human and ecological health.
Biodegradation of HMW-PAHs by microorganisms is one of the main ways to remove them from the environment. Various microbial and fungal groups have been found to be capable of utilizing PAHs—including naphthalene, phenanthrene, and pyrene—as sole carbon sources, or to co-metabolize PAHs [3,4,5]. Specific exogenous microorganisms—such as bacteria and fungi, which have better degrading capabilities for a wider range of aromatic compounds—are usually introduced into the soil to enhance the degradation rate. Furthermore, the rhizosphere is the interface between plant roots and soil where interactions among a myriad of microorganisms and invertebrates affecting biogeochemical cycling, plant growth, and tolerance to biotic and abiotic stress [6]. Moreover, bacteria that are found in plant species but do not visibly harm host plants are called endophytic bacteria. Philippot et al. (2013) suggested that plants can transmit specific microorganisms from one generation to another, and several endophytes were able to exit the root interior to colonize the rhizosphere [6]. Berg et al. (2005) also reported that these endophytic bacteria often belong to specific genera commonly found in soil [7]. Several PAH-degrading endophytic bacteria, which could degrade PAHs in plant tissues, have been isolated from plants grown in PAH-contaminated soils [8,9].
All the plants have the possibility to be the host plants, and specific endophytic bacteria colonizing internal tissues of host plants could effectively stimulate certain transcription levels of specific genes [10]. Soleimani et al. (2010) reported that inoculated plants created higher levels of water-soluble dehydrogenase activity, which is an important enzyme in the biodegradation of PAHs [11]. Plants can provide co-substrates for bacteria to enhance biodegradation of HMW-PAHs [12]. Thus, we hypothesized that highly PAH-degrading endophytic bacteria can be applied in order to reduce the accumulation of PAHs in plant tissues. As such, inoculating plants with PAH-degrading endophytic bacterial strains would represent a potential manner in which to decrease PAH contamination in plants.
For this purpose, more PAH-degrading endophytic bacterial strains need to be isolated. The objectives of this study were to isolate PAH-degrading endophytic bacteria from PAH-contaminated plants and to evaluate their capabilities of degrading PAHs in vitro, which will be a benefit for exploring the re-colonization potential and PAH degradation performance of endophytic bacteria in a target plant. The results will provide a new perspective in the reduction of plant PAH contamination risks in PAH-contaminated sites by inoculating plants with endophytic bacteria.
2. Materials and Methods
2.1. Isolation of PAH-Degrading Endophytic Bacteria
Healthy plants (P. asiatica L., Setaria viridis (L.) Beauv., and Avena fatua L.) were collected from PAH-contaminated sites near Sinopec Yangzi Petrochemical Co., Ltd. (Nanjing, China) Each plant sample was preserved at 4 °C until further use within seven days. Luria-Bertani (LB) medium was used for the enrichment of PAH-degrading bacteria. Mineral salt (MS) medium was used as the basal medium for isolating PAH-degrading endophytic bacteria and evaluating the capabilities of these microbes for degrading PAHs. Phenanthrene was used for the isolation of endophytic bacteria as a representative of PAHs. Stock solutions of individual and PAH mixtures were prepared in methanol and used in all degradation experiments.
Plant tissues were sterilized after being immersed in 75% (v/v) ethanol-water solution for 3–5 min and immersed in 0.1% (v/v) mercuric chloride solution for 3–5 min. Subsequently, these plant tissues were washed thrice with sterile deionized water (18.2 MΩ-cm) to remove the surface sterilizing agents and were cultivated on an LB plate at 30 °C for confirmation that all external bacteria were eliminated [13]. After successfully having their surface disinfected, the plant tissues were aseptically ground.
The dilution was incubated in flasks containing 100 mL of MS media supplemented with 50 mg·L−1 of phenanthrene. The aliquots were transferred weekly to fresh MS medium supplemented with 50 mg·L−1 of phenanthrene at least four times prior to the isolation of the bacterial strains. All flasks were incubated in the dark on a rotary shaker at 30 °C and 150 r·min−1. Isolation and purification procedures were performed on MS medium agar plates coated on the surface with a layer of 50 mg·L−1 phenanthrene, and subsequently incubated at 30 °C. The size and color of the isolated colonies were recorded. The bacterial strains were selected based on colony morphology and color.
2.2. Identification of PAH-Degrading Endophytic Bacteria
The strain was classified based on 16S rRNA gene sequence analysis and its physiological and biochemical characters. The biochemical characters of strain PHE-3 were tested according to the methods described by Dong and Cai (2001) [14]. 16S rRNA gene fragments from the isolated strains were prepared following the method described by Byers et al. (1998) [15]; genomic DNA was used as a template to amplify the extracted 16S rRNA gene fragments through PCR using the universal primers 16S-27F (5′-AGAGTTTGATCCTGGCTCAG-3′) and 16S-1492R (5′-TACCTTGTTACGACTT-3′) (Invitrogen Co., Ltd., Shanghai, China). The amplification reactions were performed on a DNA Engine Thermal Cycler (PTC-200, BIO-RAD, Foster City, CA, USA). The 25-μL PCR mixture contained 1-μL template, 2.5 μL of 10 × Taq DNA polymerase buffer, 5 mmol·L−1 MgCl2, 1-μL dNTPs at 2.5 mmol·L−1, 3.75 pmol each of the forward and reverse primers, and 0.5 mL of 2.5 units Taq polymerase. Sequencing was performed at the Nanjing Genscript Biotechnology Company, Limited (Nanjing, China). The 16S rRNA gene sequences were queried against the GenBank database [16] and the microgenetic analysis was performed using the Clustalx 1.83 and MEGA 6.0 programs.
2.3. Biodegradation of PAHs by Endophytic Bacterium
Ten phenanthrene-degrading endophytic bacterial strains, which could use phenanthrene as the sole source of carbon and energy, were isolated through a selective enrichment culture procedure. Among them, strain PHE-3 and strain PHE-5 could degrade more than 90% phenanthrene in the medium within seven days. Since strain PHE-5 (Stenotrophomonas maltophilia sp.) was identified as a pathogenic bacterium, strain PHE-3 isolated from (P. asiatica L.) was selected for further investigation. The cells were used as inocula in degradation studies after reaching the stationary phase through suspension in fresh MS medium at an optical density OD600 nm of 1.0 (108 cells·mL−1). The degradation of PAHs was monitored in 50-mL flasks containing 20 mL of MS medium containing PAHs as the sole carbon sources, and 1-mL aliquots of the strain suspension were added to the prepared flasks. The control flasks were inoculated with sterilized MS medium to assess the impact of abiotic factors on the PAHs stability. All cultures were incubated on a rotary shaker (150 r·min−1) at 30 °C.
2.3.1. Capacity of Degrading Phenanthrene
To measure the degradation rates of phenanthrene by strain PHE-3, strains were cultivated in MS medium supplemented with 50 mg·L−1 phenanthrene as the sole carbon source for 96 h. Triplicate flasks were retrieved every 12 h for detection of PAH levels, using degradation kinetics equations to represent the biodegradation ability.
To assess the effects of the initial phenanthrene levels on the biodegradation of phenanthrene, strains were cultivated in the MS media supplemented with phenanthrene at 25, 50, 100, 200, and 300 mg·L−1, respectively. After 96 h cultivation, triplicate flasks from each treatment were retrieved for detection of phenanthrene levels.
The temperature experiments included temperatures of 20, 30, 37, and 42 °C. In the pH experiments, the initial pH value of the MS medium was adjusted to 4.0, 5.0, 6.0, 7.0, 8.0, 9.0, and 10.0. After 96 h incubation, triplicate flasks from each treatment were retrieved for the detection of phenanthrene residues.
2.3.2. Activities of Catechol 2,3-dioxygenase
The strains were cultivated in the MS media supplemented with phenanthrene at 25, 50, 100, 200, and 300 mg·L−1. After 84 h cultivation, quadruplicate flasks from each treatment were retrieved for the detection of catechol 2,3-dioxygenase (C2,3O) activities. The culture broth was harvested and centrifuged at 8000 r·min−1 for 5 min at 4 °C to collect cells. For determination of C2,3O activity, the cell paste was resuspended in 10 mmol·L−1 phosphate buffer (pH 7.5) and disrupted with an ultrasonic oscillator at 200 W in an ice bath for 30 min. Particulate matter was removed from the extract by centrifugation at 12,000 r·min−1 for 30 min at 4 °C. The supernatant was used for the assay of C2,3O activity, which was according to published spectrophotometric procedure [17]. The reaction mixture (total 3.0 mL) contained 2.2 mL phosphate buffer, 0.4 mL 20 μmol·L−1 catechol, and 0.4 mL cell lysates. The increase of absorbance due to the formation of 2-hydroxy-muconic semialdehyde was measured at 375 mm. One unit of its specific activity is defined as the increase of 0.001 OD·min−1.
2.3.3. Capabilities of Degrading Other PAHs
Capabilities of Degrading Other PAHs Separately
One 2-ringed PAH (naphthalene), two 3-ringed PAHs (fluorene and phenanthrene), two 4-ringed PAHs (fluoranthene and pyrene), and one 5-ringed PAH (Benzo[a]pyrene) were selected as representatives for PAHs to investigate the capability of strain PHE-3 to biodegrade PAHs. The strains were cultivated in MS medium supplemented with PAH separately. The initial concentration of each PAH in the medium was as follows: 500 mg·L−1 naphthalene, 100 mg·L−1 fluorene, 100 mg·L−1 phenanthrene, 100 mg·L−1 fluoranthene, 50 mg·L−1 pyrene, and 10 mg L−1 benzo[a]pyrene. After 7 d cultivation, triplicate flasks from each treatment were retrieved for detection of PAH levels.
Capacities of Degrading a Mixture of PAHs
The aliquots were suspended in the MS medium supplemented with a mixture of six PAHs, including 500 mg·L−1 naphthalene, 100 mg·L−1 fluorene, 50 mg·L−1 phenanthrene, 50 mg·L−1 fluoranthene, 50 mg·L−1 pyrene, and 10 mg·L−1 benzo[a]pyrene. After 7 d cultivation, triplicate flasks from each treatment were retrieved for detection of PAH levels.
2.4. Effects of Additional Nutrients on Phenanthrene Degradation
Glucose, sucrose, citric acid, and yeast were selected as the representatives for carbon nutrients, and NH4NO3, (NH4)2SO4, glutamate, and tryptone were selected as the representatives for nitrogen nutrients. The aliquots were suspended in the MS medium supplemented with 100 mg·L−1 phenanthrene and each of the additional nutrients at 50 mg·L−1. After 84 h cultivation, triplicate flasks from each treatment were retrieved for detection of PAH levels.
2.5. Detection of PAH Residues by HPLC
The PAHs were extracted from the MS media with methanol, which was added to the medium at the ratio of 7:3 (v/v), ultrasonically extracted for 30 min, and centrifuged at 12,000 r·min−1 for 10 min, followed by filtration through 0.22-µm filters.
The PAH levels in the prepared samples were quantified using a high-performance liquid chromatography (HPLC; LC-20AT; Shimadzu, Kyoto, Japan) equipped with a 4.6 × 150-mm reverse-phase C18 column using methanol-water (90:10) as the mobile phase at a flow rate of 0.8 mL·min−1. Chromatography was performed at 40 °C using a detection wavelength of 245 nm.
2.6. Statistical Analyses
The statistical significance of any differences between treatments was subjected to one-way analysis of variance (ANOVA). Differences with p values < 0.05 were considered statistically significant. The kinetics equations for PAH degradation by strain PHE-3 were calculated using regression analyses.
3. Results and Discussion
3.1. Isolation and Identification of Strain PHE-3
The endophytic strain PHE-3 was isolated from P. asiatica L. grown in a PAH-contaminated soil, which could utilize phenanthrene (up to 300 mg·L−1) as the sole source of carbon and energy. The colonies and a cell micrograph of strain PHE-3 are shown in Figure 1. The physiological and biochemical characteristics are presented in Table 1. The colonies of strain PHE-3 showed faint yellow color, and were small, round, semitransparent, and convex with a glistening surface and an irregular shape with a slightly serrated border (Figure 1a). The cells of strain PHE-3 were long, aerobic, with peritrichous and a large number of extracellular polysaccharide, and gram-positive rods (Figure 1b). Strain PHE-3 could hydrolyze starch, although the results for the other reactions were negative (Table 1).
Figure 1.
Photograph of (a) colonies of strain PHE3 on a Luria-Bertani (LB) medium plate and (b) electron micrograph of strain PHE-3 (×3.0 K).

Table 1.
Physiological and biochemical characters of strain PHE-3.
Based on BLAST sequence comparison, the 16S rRNA of strain PHE-3 was 99.0% similar to that of Paenibacillus sp. (Figure 2). According to its 16S rRNA, and its physiological and biochemical characters, strain PHE-3 could be considered a Paenibacillus sp. strain, a genus which has typically been found to have the capability of promoting plant growth [18]. Previous research suggested that Paenibacillus stains had great potential for degrading various persistent organic pollutants (POPs), including kraft lignin [19], dibenzothiophene (DBT) and alkyl DBTs [20], hexenuronic acid [21], and PAHs [22]. Some bacteria belonging to the Paenibacillus genus that were isolated from the petroleum-contaminated sediment and salt marsh rhizosphere could use naphthalene or phenanthrene as a sole carbon source [23]. Moreover, several Paenibacillus sp. strains were found to have the capability of both using PAHs and tolerating higher concentrations of arsenic, cadmium, and lead [24]. Furthermore, Paenibacillus strains were usually found to be able to increment plant growth [25], and produce a novel biosurfactant that was capable of desorbing PAHs from soil and assisting with the removal of PAHs [26].

Figure 2.
Phylogenetic tree of 16S rRNA gene sequence for strain PHE-3 and related bacteria.
3.2. Biodegradation of Phenanthrene by Strain PHE-3
As shown in Figure 3a, phenanthrene was rapidly degraded after 24 h, and the degradation rates were low during the first 24 h. The residual of phenanthrene and the cultivation time had a significant negative correlation (ρ = −0.954, p < 0.01). The degradation kinetics of phenanthrene (50 mg·L−1) was shown as an equation. From this equation, the half-life (T1/2) value of phenanthrene was 23 h, thereby suggesting that phenanthrene could be quickly degraded by strain PHE-3.
where Cphenanthrene represents the residual concentrations of phenanthrene in the medium (mg·L−1), and t represents the incubation time (h).
Cphenanthrene = 123.73 × е‒0.0302 t (by strain PHE-3, r = 0.7135)

Figure 3.
Biodegradation of phenanthrene by strain PHE-3 at different cultivation times (a) and under different initial concentrations (b) at 30 °C for 96 h. Different lowercase letters indicate significant differences among treatments (p < 0.05).
Strain PHE-3 could effectively degrade phenanthrene at 50, 100, 150, 200, 250, and 300 mg·L−1, while the degradation rates significantly decreased with the increasing phenanthrene levels (ρ = −0.978, p < 0.01) (Figure 3b). When the levels of phenanthrene were less than 100 mg·L−1, the degradation rates of phenanthrene were more than 77% after 4 d inoculation.
3.3. Catechol 2,3-dioxygenase Activity
C2,3O is a member of the super family of extradiol dioxygenases, and catalyzes the ring cleavage of catechol and substituted catechols. It is also an important mechanism to degrade PAHs by bacteria [27]. Given the activities of C2,3O with respect to the utilization of low molecular weight PAHs (LMW-PAHs) and HMW-PAHs [28], C2,3O activities were detected in order to evaluate the capability of strain PHE-3 to degrade PAHs. As shown in Figure 4, phenanthrene promoted C2,3O activity, and the biodegradation of phenanthrene was positively correlated with the C2,3O activity (ρ = 0.981, p < 0.05). The C2,3O level showed a peak in the medium with 50 mg·L−1 phenanthrene, while the C2,3O activities decreased with increasing phenanthrene levels when phenanthrene levels were more than 50 mg·L−1 (ρ = 0.990, p < 0.05), thereby suggesting that reduction of the C2,3O activities might be the reason why the biodegradation of phenanthrene occurred less in the media with high levels of phenanthrene (200, 250, and 300 mg·L−1). Based on its promotion of C2,3O activities, strain PHE-3 might have the capability to degrade HMW-PAHs.

Figure 4.
Catechol 2,3-dioxygenase activities of strain PHE-3 cultivated in the medium with different levels of phenanthrene at 30 °C after 84 h. Different lowercase letters indicate significant differences among treatments (p < 0.05).
3.4. Biodegradation of Other PAHs
After being cultivated in a medium containing either a individual PAH or a mixture of six PAHs, strain PHE-3 was able to simultaneously degrade naphthalene, fluorene, phenanthrene, fluorene, pyrene, and benzo[a]pyrene (Figure 5). High efficiency was observed for naphthalene degradation in strain PHE-3, which was similar to another Paenibacillus strain reported by Pepi (2009) which degraded 87% naphthalene from media after 20 h incubation [24]. Moreover, the degradation of PAHs occurred rapidly, with 53.2% of the fluorene, 44.0% of the pyrene, and 57.7% of the benzo[a]pyrene having degraded after seven days by inoculating strain PHE-3 in the medium containing a mixture of PAHs; however, only 24.4% of the fluorene, 24.2% of the pyrene, and 22.1% of the benzo[a]pyrene were degraded in the absence of other PAHs during the same period.

Figure 5.
Biodegradation of polycyclic aromatic hydrocarbons (PAHs) by PHE-3 cultivation in the medium with a single PAH or a mixture of PAHs at 30 °C after 7 d. Different lowercase letters indicate significant differences among treatments (p < 0.05). Note: Naphthalene (NAP), Fluorene (FLR), Phenanthrene (PHE), Pyrene (PYR), Fluoranthene (FLT), and Benzo[a]pyrene (BaP).
These results suggested that naphthalene, fluorine, and phenanthrene were supplied as co-substrates; the degradation of fluorene, pyrene, and benzo[a]pyrene proceeded at a relatively rapid rate compared to the rate which degradation occurred when the substrates were alone. Paenibacillus sp. PHE-3 could biodegrade PAHs through co-metabolism, as it was found by Thavamani et al. (2012) that Paenibacillus sp. PHE-3 could use phenanthrene as a co-substrate for degradation of benzo[a]pyrene [29]. Since HMW-PAHs are quite tolerant to microbial attack, until now, the reported degradation rate of benzo[a]pyrene by microorganisms was generally quite modest. Due to its co-metabolism, strain PHE-3 would have great potential for bioremediation of HMW-PAHs. However, the biodegradation of phenanthrene was inhibited in presence of HMW-PAHs. Zhong et al. reported that pyrene and fluoranthene could inhibit the production of 1-hydroxy-2-naphthoic acid to decrease the biodegradation of phenanthrene (2010) [30]. For improving its biodegradation of phenanthrene, the optimal conditions were evaluated in the following study.
3.5. Optimal Environmental Conditions for Biodegradation of Phenanthrene
3.5.1. pH and Temperature
Several bacteria were reported to effectively biodegrade PAHs in the medium with initial pH from 4.0 to 10.0 [31,32]. To test optimal pH of the medium for strain PHE-3, the degradation tests were performed at initial pH from 4.0 to 10.0, and temperatures from 20 to 42 °C (Figure 6a). Similar to other bacteria reported by Fu and Lin, strain PHE-3 could effectively biodegrade phenanthrene (more than 99%) when the initial pH of the media were between 4.0–8.0, and an initial pH value of 8.0 was key in the degradation of phenanthrene [31,32]. The degradation of phenanthrene decreased with increasing pH values when the pH of the medium was more than 8.0 (ρ = –0.795, p < 0.05). Meanwhile, the biodegradation rates of phenanthrene by strain PHE-3 were more than 93% when the cultivation temperature were from 30 to 42 °C, while the biodegradation rate was 19% at 20 °C (Figure 6b). These results show that the optimal conditions for strain PHE-3 to degrade phenanthrene were as follows: pH between 4.0–8.0 and temperature between 30 °C–42 °C, thereby suggesting that strain PHE-3 could perform well under high temperature and alkalescent condition. Ferguson et al. (2008) also found that a Paenibacillus strain was capable of rapidly mineralizing hydrocarbons at 42 °C in an Antarctic hydrocarbon-contaminated site [33].

Figure 6.
Effects of pH (a) and temperature (b) on the degradation of phenanthrene by PHE-3. Bacteria were grown in a mineral salt (MS) medium supplemented with 50 mg·L−1 phenanthrene, and phenanthrene levels in the culture supernatant were detected after 7 d of incubation (30 °C in Figure 6a; pH 7.0 in Figure 6b). Different lowercase letters indicate significant differences among treatments (p < 0.05).
3.5.2. Additional Carbon and Nitrogen Nutrients
The degradation of phenanthrene could be enhanced by adding additional carbon and nitrogen nutrients (Table 2). The degradation rates of phenanthrene were all more than 95% after 84 h cultivation with additional nutrients (p < 0.05). When glucose, sucrose, citric acid, and yeast were separatedly added in the medium, the degradation rates of phenanthrene were increased by 22.2%, 24.7%, 26.3% and 26.3%, respectively (p < 0.05). In addition, the degradation was also significantly enhanced by nitrogen nutrients including NH4NO3, (NH4)2SO4, glutamate, and tryptone (Table 2). Additional glutamate enhanced phenanthrene degradation by 22.5%–26.78% and achieved maximal degradation rates (99.9%) in our study (p < 0.05). These results suggest that strain PHE-3 has some potential of co-metabolism, which is supported by previous research that found that LMW-organic compounds could enhance the biodegradation of HMW-PAHs via co-metabolism [34,35]. Likewise, this is the same as for other bacteria, whose degradation of PAHs could be enhanced by adding nitrogen nutrients [36]. Since these beneficial organic compounds and nitrogen nutrients (including glucose, sucrose, citric acid, NH4NO3, (NH4)2SO4, glutamate, and tryptone) can be found in plant tissues, strain PHE-3 would degrade PAHs well in plant tissues.

Table 2.
Effects of additional nutrients on the degradation of phenanthrene. Bacteria were grown in MS medium supplemented with 100 mg·L−1 phenanthrene and each of the other additional nutrients. Phenanthrene levels in the culture supernatant were detected after 84 h of incubation (at 30 °C, pH 7.0).
3.6. Possible Application for PAH-Degrading Endophytic Bacteria
It has been reported that endophytic Paenibacillus strains could be inoculated in plants and promote plant growth. The plant growth-promoting activities of endophytic Paenibacillus strains included N2-fixing [37], forming biofilm to display greater biocontrol, and increasing chlorophyll content in plants [18]. In our study, the endophytic bacterial strain Paenibacillus sp. PHE-3 could effectively degrade PAHs in vitro, indicating it could be beneficial for re-colonizing a target plant for reducing the risk of plant PAH contamination.
4. Conclusions
Endophytes with the capacity to highly degrade PAHs in vitro may have significant implications for re-colonizing a target plant and reducing PAHs residue in vivo. In our study, endophytic Paenibacillus sp. PHE-3, which could effectively degrade naphthalene, fluorene, phenanthrene, fluoranthene, pyrene, and benzo[a]pyrene both separately and together, was isolated from P. asiatica L. that was grown in PAH-contaminated soil. The biodegradation of PAHs could be enhanced by some co-substrates including LMW-PAHs, suggesting that strain PHE-3 might perform well in PAH-contaminated plants. Our results will provide a novel endophytic bacterium for bioremediation of PAH-contaminated sites and plants.
Acknowledgments
This work was financially supported by the National Natural Science Foundation of China (31270574, 21477056).
Author Contributions
Xuezhu Zhu and Wanting Ling designed the experiments, analyzed the data, and wrote the paper; Li Jin performed the experiments on enrichment, isolation, and identification of endophytic bacteria; Kai Sun analyzed the degradation and evaluated the culture conditions; Shuang Li analyzed the activities of the enzyme; Xuelin Li collected the samples of plants grown in contaminated sites. All authors evaluated and revised the manuscript writing.
Conflicts of Interest
The authors declare no conflict of interest.
References
- Kanaly, R.A.; Harayama, S. Advances in the field of high molecular-weight polycyclic aromatic hydrocarbon biodegradation by bacteria. Microb. Biotechnol. 2010, 3, 136–164. [Google Scholar] [CrossRef] [PubMed]
- Tao, S.; Cui, Y.H.; Xu, F.L.; Li, B.G.; Cao, J.; Liu, W.X.; Schmitt, G.; Wang, X.J.; Shen, W.R.; Qing, B.P.; et al. Polycyclic aromatic hydrocarbons (PAHs) in agricultural soil and vegetables from Tianjin. Sci. Total Environ. 2004, 320, 11–24. [Google Scholar] [CrossRef]
- Su, D.; Li, P.J.; Frank, S.; Xiong, X.H. Biodegradation of benzo[a]pyrene in soil by Mucor sp. SF06 and Bacillus sp. SB02 co-immobilized on vermiculite. J. Environ. Sci. 2006, 18, 1204–1209. [Google Scholar] [CrossRef]
- Wu, Y.R.; Luo, Z.H.; Vrijmoed, L.L.P. Biodegradation of anthracene and benz[a]anthracene by two Fusarium solani strains isolated from mangrove sediments. Bioresour. Technol. 2010, 101, 9666–9672. [Google Scholar] [CrossRef] [PubMed]
- Wen, J.W.; Gao, D.W.; Zhang, B.; Liang, H. Co-metabolic degradation of pyrene by indigenous white-rot fungus Pseudotrametes gibbosa from the northeast China. Int. Biodeterior. Biodegrad. 2011, 65, 600–604. [Google Scholar] [CrossRef]
- Philippot, L.; Raaijmakers, J.M.; Lemanceau, P.; van der Putten, W.H. Going back to the roots: The microbial ecology of the rhizosphere. Nat. Rev. Microbiol. 2013, 11, 789–799. [Google Scholar] [CrossRef] [PubMed]
- Berg, G.; Krechel, A.; Ditz, M.; Sikora, R.A.; Ulrich, A.; Hallmann, J. Endophytic and ectophytic potato-associated bacterial communities differ in structure and antagonistic function against plant pathogenic fungi. FEMS Microb. Ecol. 2005, 51, 215–229. [Google Scholar] [CrossRef] [PubMed]
- Sun, K.; Liu, L.; Jin, L.; Gao, Y.Z. Utilizing pyrene-degrading endophytic bacteria to reduce the risk of plant pyrene contamination. Plant Soil 2014, 374, 251–262. [Google Scholar] [CrossRef]
- Sun, K.; Liu, J.; Gao, Y.; Jin, L.; Gu, Y.; Wang, W. Isolation, plant colonization potential, and phenanthrene degradation performance of the endophytic bacterium Pseudomonas sp. Ph6-gfp. Sci. Rep. 2014, 4, 5462. [Google Scholar] [CrossRef] [PubMed]
- Li, J.; Zhao, G.Z.; Varma, A.; Qin, S.; Xiong, Z.; Huang, H.Y.; Zhu, W.Y.; Zhao, L.X.; Xu, L.H.; Zhang, S.; et al. An Endophytic Pseudonocardia Species Induces the Production of Artemisinin in Artemisia annua. PLoS ONE 2012, 7, 1–10. [Google Scholar] [CrossRef] [PubMed]
- Soleimani, M.; Afyuni, M.; Hajabbasi, M.A.; Nourbakhsh, F.; Sabzalian, M.R.; Christensen, J.H. Phytoremediation of an aged petroleum contaminated soil using endophyte infected and non-infected grasses. Chemosphere 2010, 81, 1084–1090. [Google Scholar] [CrossRef] [PubMed]
- Parellada, E.A.; Ramos, A.N.; Ferrero, M.; Cartagena, E.; Bardon, A.; Neske, A. Effect of the annonaceous acetogenins, squamocin and laherradurin, on the degradation of naphthalene mediated by Pseudomonas plecoglossicida J26. Int. Biodeterior. Biodegrad. 2012, 72, 82–87. [Google Scholar] [CrossRef]
- Weyens, N.; Truyens, S.; Dupae, J.; Newman, L.; Taghavi, S.; van der Lelie, D.; Carleer, R.; Vangronsveld, J. Potential of the TCE-Degrading endophyte pseudomonas putida W619-TCE to improve plant growth and reduce TCE phytotoxicity and evapotranspiration in poplar cuttings. Environ. Pollut. 2010, 158, 2915–2919. [Google Scholar] [CrossRef] [PubMed]
- Dong, X.Z.; Cai, M.Y. Manual of Systematic Identification for Common Bacteria; Science Press: Beijing, China, 2001; pp. 80–110. (In Chinese) [Google Scholar]
- Byers, H.K.; Stackebrandt, E.; Hayward, C.; Blackall, L.L. Molecular investigation of a microbial mat associated with the Great Artesian Basin. FEMS Microbiol. Ecol. 1998, 25, 391–403. [Google Scholar] [CrossRef]
- GenBank Database. Available online: http://www.ncbi.nlm.nih.gov/ (accessed on 1 June 2016).
- Tian, L.; Ma, P.; Zhong, J.J. Kinetics and key enzyme activities of phenanthrene degradation by Pseudomonas mendocina. Process Biochem. 2002, 37, 1431–1437. [Google Scholar] [CrossRef]
- Herrera, S.D.; Grossi, C.; Zawoznik, M.; Groppa, M.D. Wheat seeds harbour bacterial endophytes with potential as plant growth promoters and biocontrol agents of Fusarium graminearum. Microbiol. Res. 2016, 186, 37–43. [Google Scholar] [CrossRef] [PubMed]
- Chandra, R.; Raj, A.; Purohit, H.J.; Kapley, A. Characterisation and optimisation of three potential aerobic bacterial strains for kraft lignin degradation from pulp paper waste. Chemosphere 2007, 67, 839–846. [Google Scholar] [CrossRef] [PubMed]
- Ishii, Y.; Konishi, J.; Okada, H.; Hirasawa, K.; Onaka, T.; Suzuki, M. Operon structure and functional analysis of the genes encoding thermophilic desulfurizing enzymes of Paenibacillus sp. A11–2. Biochem. Biophys. Res. Commun. 2000, 270, 81–88. [Google Scholar] [CrossRef] [PubMed]
- Septiningrum, K.; Ohi, H.; Waeonukul, R.; Pason, P.; Tachaapaikoon, C.; Ratanakhanokchai, K.; Sermsathanaswadi, J.; Deng, L.; Prawitwong, P.; Kosugi, A. The GH67α-glucuronidase of Paenibacillus curdlanolyticus B-6removes hexenuronic acid groups and facilitates biodegradation of the model xylooligosaccharide hexenuronosyl xylotriose. Enzyme Microb. Tech. 2015, 71, 28–35. [Google Scholar] [CrossRef] [PubMed]
- AL-Saleh, E.; Obuekwe, C. Crude oil biodegradation activity in potable water. Int. Biodeterior. Biodegrad. 2014, 93, 18–24. [Google Scholar] [CrossRef]
- Daane, L.L.; Harjono, I.; Barns, S.M.; Launen, L.A.; Palleroni, N.J.; Haggblom, M.M. PAH-degradation by Paenibacillus spp. and description of Paenibacillus naphthalenovorans sp. nov., a naphthalene degrading bacterium from the rhizosphere of salt marsh plants. Int. J. Syst. Evol. Microbiol. 2002, 52, 131–139. [Google Scholar] [CrossRef] [PubMed]
- Pepi, M.; Lobianco, A.; Renzi, M.; Perra, G.; Bernardini, E.; Marvasi, M.; Gasperini, S.; Volterrani, M.; Franchi, E.; Heipieper, H.J.; et al. Two naphthalene degrading bacteria belonging to the genera Paenibacillus and Pseudomonas isolated from a highly polluted lagoon perform different sensitivities to the organic and heavy metal contaminants. Extremophiles 2009, 13, 839–848. [Google Scholar] [CrossRef] [PubMed]
- Castanheira, N.; Dourado, A.C.; Alves, P.I.; Cortes-Pallero, A.M.; Delgado-Rodriguez, A.I.; Prazeres, A.; Borges, N.; Sanchez, C.; Crespo, M.T.B.; Fareleira, P. Annual ryegrass-associated bacteria with potential for plant growth promotion. Microbiol. Res. 2014, 169, 768–779. [Google Scholar] [CrossRef] [PubMed]
- Bezza, F.A.; Chirwa, E.M.N. Biosurfactant from Paenibacillus dendritiformis andits application in assisting polycyclic aromatic hydrocarbon (PAH) and motor oil sludge removal from contaminated soil and sand media. Process Saf. Environ. 2015, 98, 354–364. [Google Scholar] [CrossRef]
- Hadibarata, T.; Tachibana, S.; Itoh, K. Biodegradation of chrysene, an aromatic hydrocarbon by Polyporus sp. S133 in liquid medium. J. Hazard. Mater. 2009, 164, 911–917. [Google Scholar] [CrossRef] [PubMed]
- Chen, K.; Zhu, Q.; Qian, Y.G.; Song, Y.; Yao, J.; Choi, M.M.F. Microcalorimetric investigation of the effect of non-ionic surfactant on biodegradation of pyrene by PAH-degrading bacteria Burkholderia cepacia. Ecotox. Environ. Saf. 2013, 98, 361–367. [Google Scholar] [CrossRef] [PubMed]
- Thavamani, P.; Megharaj, M.; Naidu, R. Bioremediation of high molecular weight polyaromatic hydrocarbons cocontaminated with metals in liquid and soil slurries by metal tolerant PAHs degrading bacterial consortium. Biodegradation 2012, 23, 823–835. [Google Scholar] [CrossRef] [PubMed]
- Zhong, Y.; Zou, S.C.; Lin, L.; Luan, T.G.; Qiu, R.L.; Tam, N.F.Y. Effects of pyrene and fluoranthene on the degradation characteristics of phenanthrene in the cometabolism process by Sphingomonas sp. strain PheB4 isolated from mangrove sediments. Mar. Pollut. Bull. 2010, 60, 2043–2049. [Google Scholar] [CrossRef] [PubMed]
- Fu, B.; Li, Q.X.; Xu, T.; Cui, Z.L.; Sun, Y.; Li, J. Sphingobium sp. FB3 degrades a mixture of polycyclic aromatic hydrocarbons. Int. Biodeterior. Biodegrad. 2014, 87, 44–51. [Google Scholar] [CrossRef]
- Lin, M.; Hu, X.K.; Chen, W.W.; Wang, H.; Wang, C.Y. Biodegradation of phenanthrene by Pseudomonas sp. BZ-3, isolated from crude oil contaminated soil. Int. Biodeterior. Biodegrad. 2014, 94, 176–181. [Google Scholar] [CrossRef]
- Ferguson, S.H.; Powell, S.M.; Snape, I.; Gibson, J.A.E.; Franzmann, P.D. Effect of temperature on the microbial ecology of a hydrocarbon-contaminated Antarctic soil: Implications for high temperature remediation. Cold Reg. Sci. Technol. 2008, 53, 115–129. [Google Scholar] [CrossRef]
- Warshawsky, D.; LaDow, K.; Schneider, J. Enhanced degradation of benzo[a]pyrene by Mycobacterium sp. in conjunction with green alga. Chemosphere 2007, 69, 500–506. [Google Scholar] [CrossRef] [PubMed]
- Bhattacharya, S.S.; Syeda, K.; Shann, J.; Yadav, J.S. A novel P450-initiated biphasic process for sustainable biodegradation of benzo[a]pyrene in soil under nutrient-sufficient conditions by the white rot fungus Phanerochaete chrysosporium. J. Hazard. Mater. 2013, 261, 675–683. [Google Scholar] [CrossRef] [PubMed]
- Vauramo, S.; Jaaskelainen, V.; Setala, H. Environmental fate of polycyclic aromatic hydrocarbons under different plant traits in urban soil as affected by nitrogen deposition. Appl. Soil Ecol. 2011, 47, 167–175. [Google Scholar] [CrossRef]
- Ker, K.; Seguin, P.; Driscoll, B.T.; Fyles, J.W.; Smith, D.L. Switchgrass establishment and seeding year production can be improved by inoculation with rhizosphere endophytes. Biomass Bioenergy 2012, 47, 295–301. [Google Scholar] [CrossRef]
© 2016 by the authors; licensee MDPI, Basel, Switzerland. This article is an open access article distributed under the terms and conditions of the Creative Commons Attribution (CC-BY) license (http://creativecommons.org/licenses/by/4.0/).






